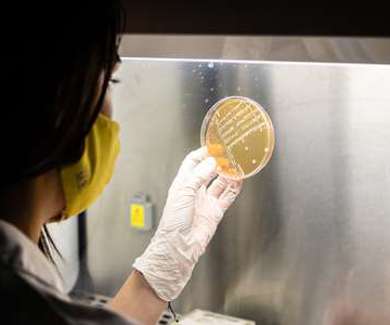
Laboratory testing

Customer Experiences
When you become a GMP+ certified company, you become a valued member of a worldwide community of feed safety experts. Let's introduce you to some of them and let them share how GMP+ certification has helped their businesses.
Shaping a safer future in feed
Blink Bioscience is a company located in Hernandarias (Paraguay), focused on the development and commercialization of innovative solutions for animal ...
Published: 14 August 2025

GMP+ ‘helps you develop your company’
Karol describes how GMP+ International has supported a group of Polish companies in finding new markets and building customer confidence.
Published: 24 June 2024

GMP+ journey ‘a profound learning experience’
Feed supplements are re-emerging, and its market is expected to grow in the coming years. María Bravo, from Spanish biotech ...
Published: 27 March 2024
‘GMP+ certification has been an enriching experience’
Terminal XXXIX de Santos is a logistics company located in the port of Santos, São Paulo (Brazil). The company specialises ...
Published: 8 February 2023

‘GMP+ is not just a standard, it’s a learning experience’
AGRAVIS Group is a well-known agricultural trading company. Based in Münster, Germany, AGRAVIS is involved in animal nutrition, crop production ...
Published: 31 October 2022

‘GMP+ gives us the opportunity to grow’
In its early years, East Grain focused mainly on the trade of quality malted wheat, covering the grain markets of ...
Published: 22 September 2022

‘GMP+ International shares knowledge with companies’
Cereal Docks is an Italian producer of ingredients derived from oilseeds and cereals. Its ingredients are used for feed, food, ...
Published: 28 June 2022

‘GMP+ offers great support to certified companies’
Nutrion produces fats & fatty acids for animal nutrition. Its main production plants are located in Spain and Indonesia, from ...
Published: 28 April 2022

‘GMP+ is not just a project, it’s a new way of working’
Hamlet Protein is a global leader in soy-based specialty ingredients for young animals. The Denmark headquartered company believes ...
Published: 28 March 2022
